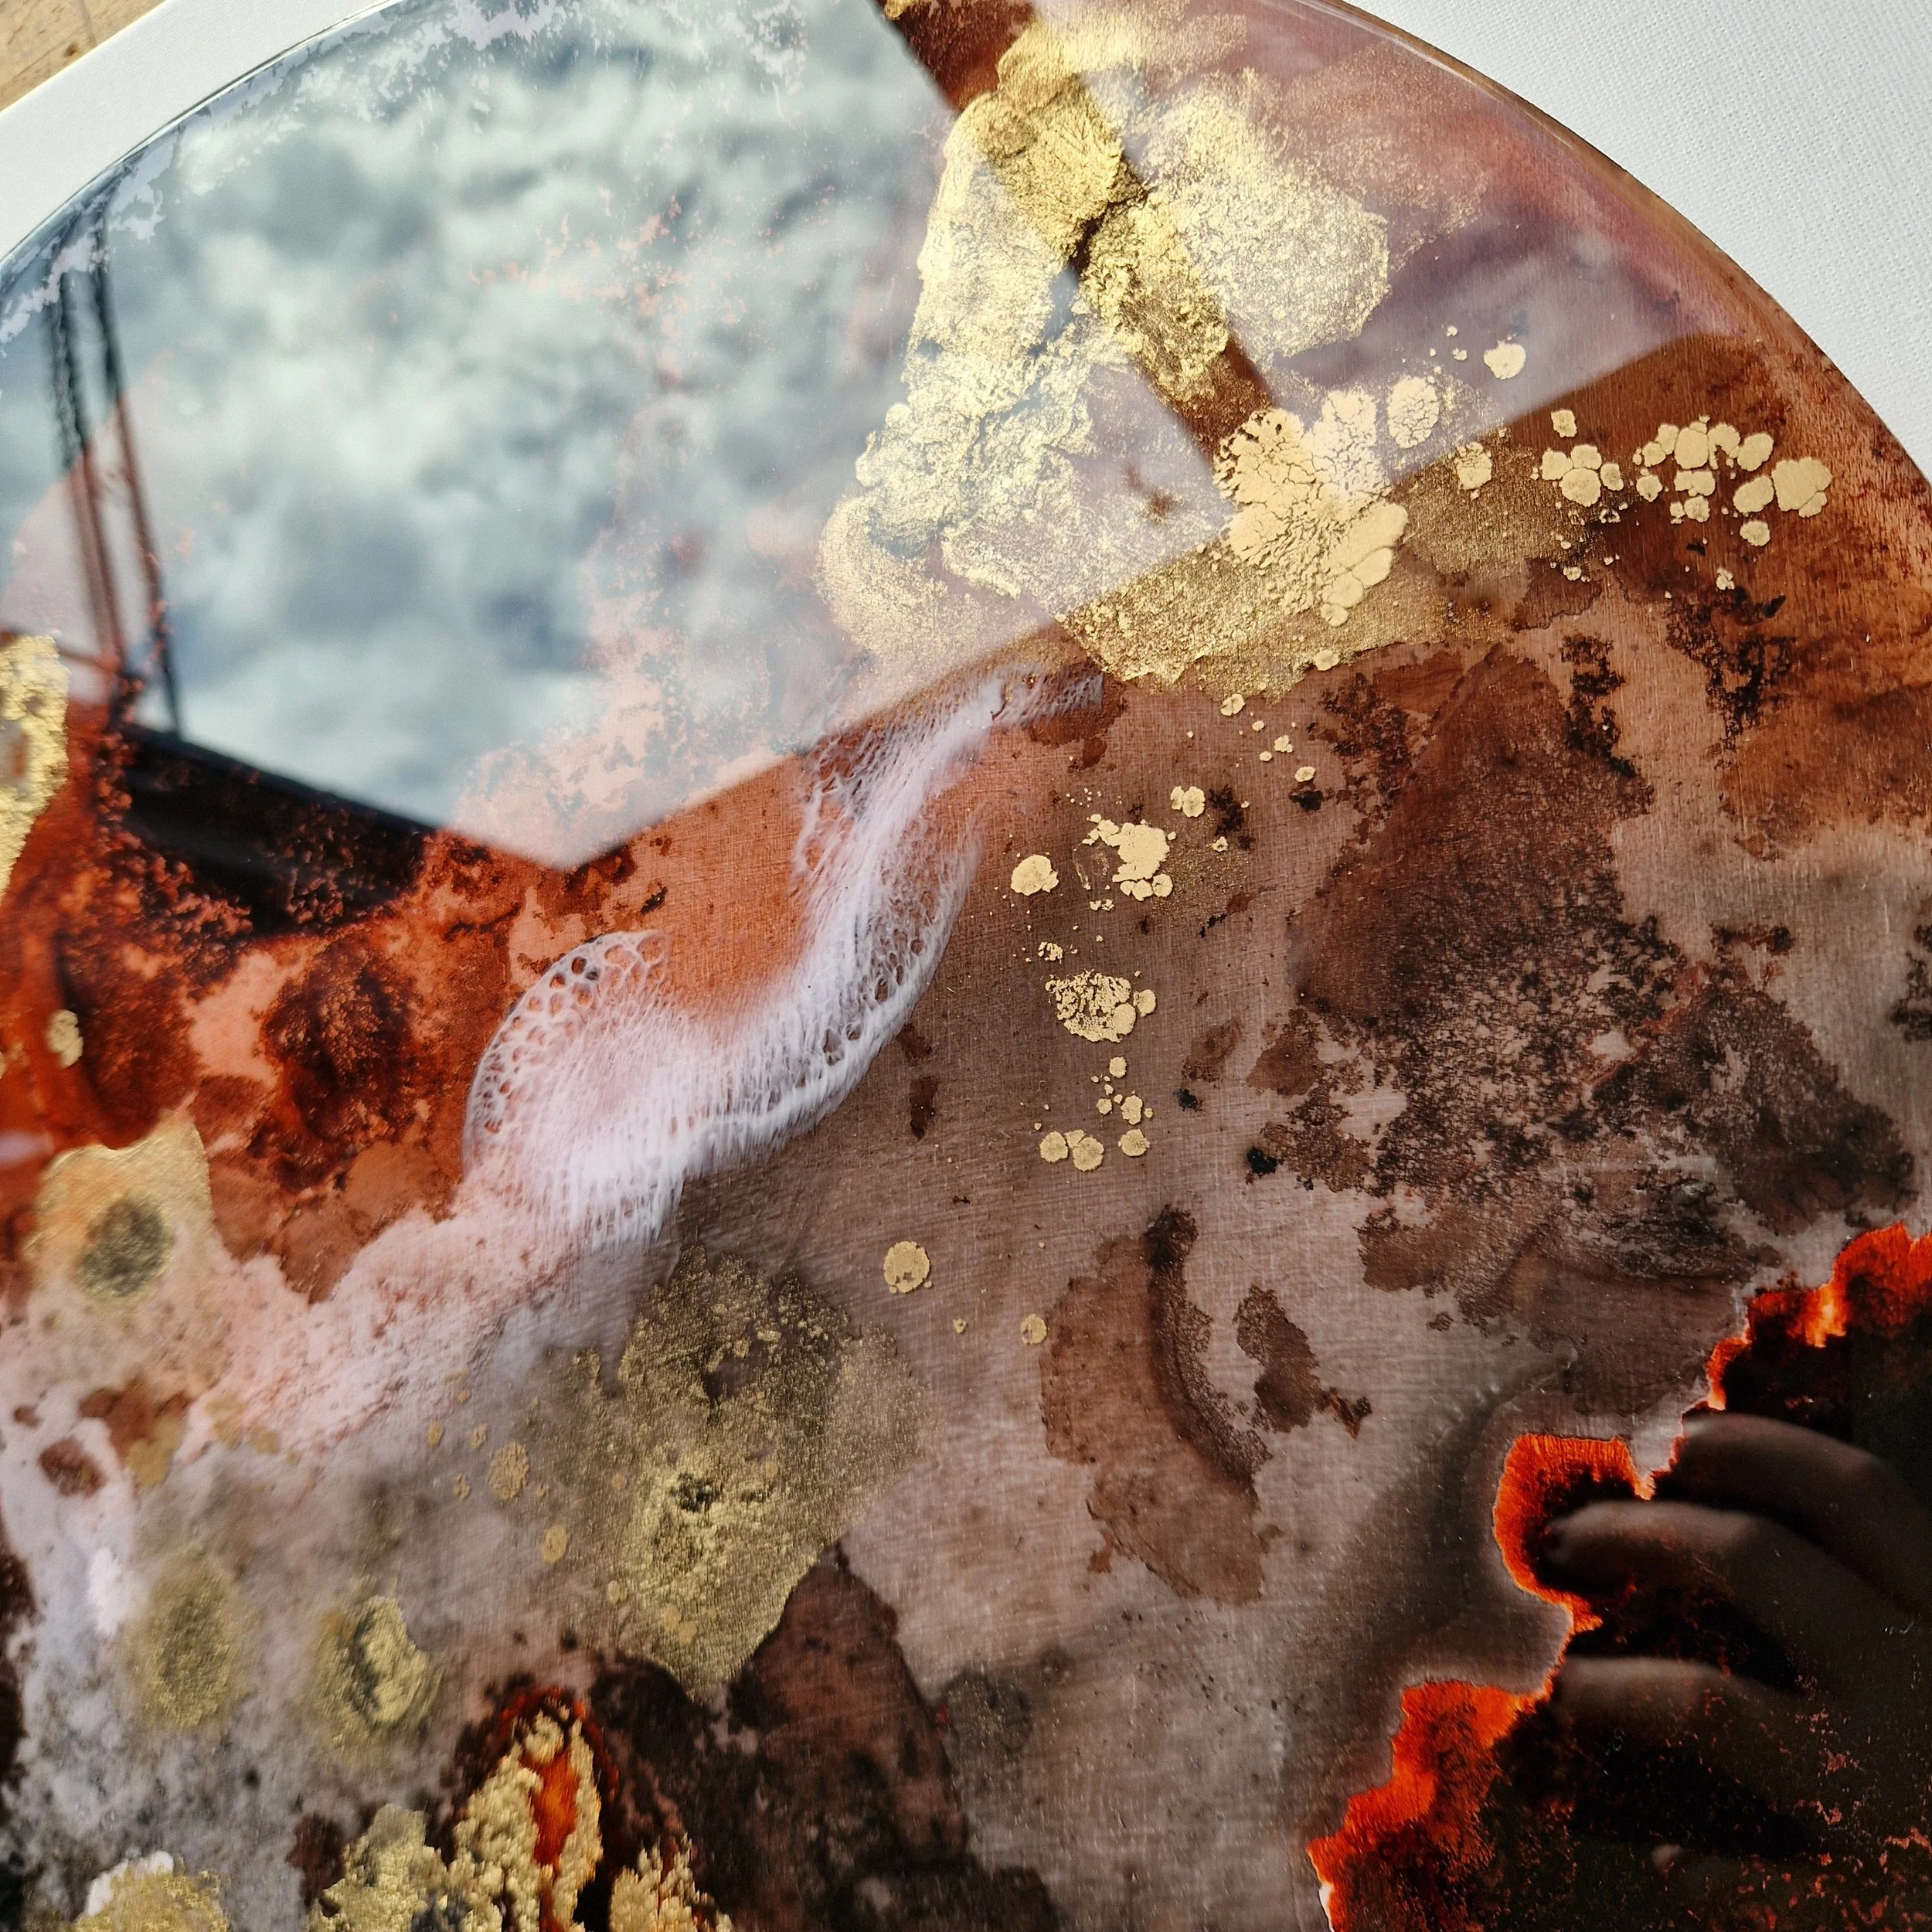

manchester Art Fair 2025
Learn about our services
-
What should we know about the services you provide? Better descriptions result in more sales.
-
What should we know about the services you provide? Better descriptions result in more sales.
-
What should we know about the services you provide? Better descriptions result in more sales.